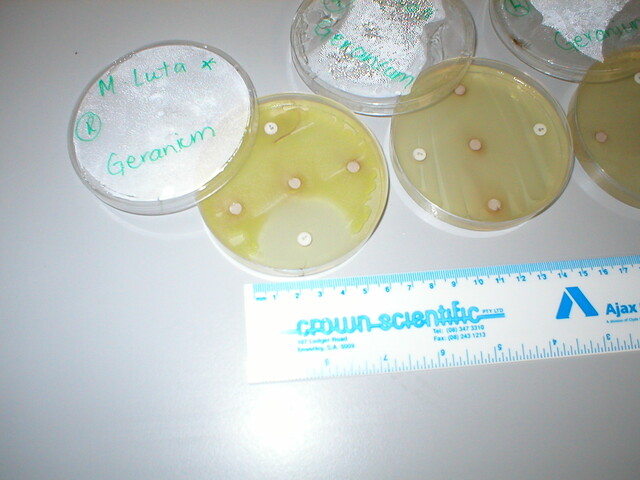

Crash course on research
Digital Edition
Subscribe
Get an all ACCESS PASS to the News and your Digital Edition with an online subscription
Warriors edge out YCW
WHYALLA - The most anticipated matchup of the 2026 Whyalla netball season took place on Saturday, with the two top teams in Warriors and...







